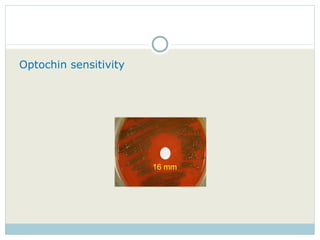
Optochin sensitivity   16 mm
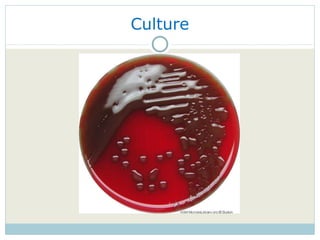
Culture

The document summarizes information about Streptococcus pneumoniae (pneumococcus):
1. It is a gram-positive coccus that appears in pairs (diplococci) or chains under microscopy. It is identified by being alpha-hemolytic, optochin-sensitive, and exhibiting a Quellung reaction showing its polysaccharide capsule.
2. Pneumococcus is a common cause of pneumonia as well as other invasive diseases. Virulence factors like its polysaccharide capsule allow it to evade the immune system and cause disease.
3. Treatment involves penicillins or other antibiotics. Vaccines targeting the 90+ capsular serotypes help prevent pneumococcal disease.